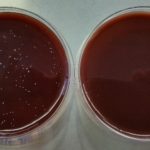
Utilizzo di un nuovo sistema a pressione negativa apicale per la detersione e la disinfezione dei canali radicolari: studio ex-vivo

Regolamento europeo sulla privacy: videocorso su obiettivi e soluzioni per lo studio odontoiatrico
Il Regolamento UE 679/2016, in vigore dal 25 maggio 2018, rivoluziona la materia della privacy. Questo videocorso si propone di informare con un approccio costruttivo sulle novità sostanziali; offrire soluzioni che agevolino i processi di acquisizione e gestione dei dati dei pazienti; semplificare ove possibile e facilitando il recepimento della normativa nello studio odontoiatrico.
Soluzioni protesiche personalizzate e digitali con tecnologia CAD-CAM
In odontoiatria, le ricostruzioni protesiche con tecnologia CAD-CAM hanno riscosso negli ultimi anni un successo crescente, perché consentono di produrre in tempi minori e con abbattimento dei costi, riabilitazioni affidabili e predicibili. Anthogyr potenzia la sua offerta di soluzioni per le ricostruzioni protesiche CAD-CAM e propone oggi i due marchi Simeda®e Connect+®.
Informazioni di qualità per ottimizzare i risultati dello studio dentistico
Il software, come qualsiasi strumento, può essere utilizzato più o meno bene. Il valore maggiore sono però le informazioni che, grazie al software, vengono immagazzinate. Riuscire ad analizzare e leggere questi dati in modo opportuno è la chiave per prendere le giuste decisioni e trarre i reali vantaggi per la propria attività.
Semilavorati e prodotti finiti in acciaio per uso ambulatoriale
In occasione dell’edizione 2018 di MECSPE, fiera di riferimento della subfornitura meccanica e dell’industria manifatturiera, grazie a uno spazio espositivo totalmente rinnovato e alla...
Destinazione: gengive sane
Nasce all'insegna della collaborazione con l’Associazione Igienisti Dentali Italiani (AIDI), il progetto "destinazione: gengive sane" che tra si svolgerà nei weekend del 13 e...
Approccio inedito all’implantologia
Con una nuova gamma, Anthogyr, grazie alla compatibilità totale tra le filosofie Bone Level e Tissue Level, propone un approccio inedito all’implantologia. L'impianto Axiom® TL (Tissue Level) offre facilità protesica, sicurezza biologica e il comfort di una protesi transavvitata in direct implant.
Simit Day 2018, l’esperienza clinica in primo piano
Il IX Simit Day, dal titolo “The Root to Crown Solution” si è tenuto il 9-10 marzo presso il Centro Congressi Veronafiere. L’obiettivo ambizioso...
Prime&Bond active: adesione efficace in diverse condizioni di umidità
Il confine tra conservativa e protesi è divenuto via via più sfumato, vedendo queste due branche dell’odontoiatria avvicinarsi per principi e materiali su cui...
#ColgateTalks: Un passo avanti nella prevenzione
I principali esperti europei del settore prevedono un ruolo sempre più importante per la prevenzione nel futuro della salute orale a causa di una...
Cassette di sterilizzazione anche personalizzabili
La realizzazione delle cassette di sterilizzazione rappresenta solo l’ultimo degli innumerevoli traguardi raggiunti da CIM nel corso di una storia di oltre cinquant’anni nel...
Compositi bulk-fill: SDR Flow+ caratteristiche ancora migliori ne aumentano le indicazioni
Le performance delle ricostruzioni che vengono eseguite nel cavo orale sono influenzate da una serie di fattori, ma di certo il più importante è...
Cassette per la sterilizzazione di strumenti odontoiatrici
Con oltre 50 anni di esperienza nelle lavorazioni di alta qualità delle materie metalliche alle spalle, con particolare attenzione agli acciai inossidabili, CIM è...
Massima affidabilità di un sistema per l’implantologia dentale
Quali sono i fattori che possono assicurare la massima affidabilità di un sistema per l’implantologia dentale? La competenza nella progettazione e nella realizzazione anzitutto. Ma anche la ricerca della qualità già a partire dalle materie prime. Oltre alla verifica dimensionale di tutti gli articoli prima della vendita.
5 milioni di pazienti: nuovo traguardo per Invisalign
5 milioni, è questo il numero di pazienti che ad oggi si sono affidati a Invisalign.
«È molto gratificante vedere come l’utilizzo della mascherina Align...
Compositi bulk-fill: semplici, veloci, di successo e adesso anche estetici
I materiali “bulk” sono sempre più utilizzati in odontoiatria perché semplificano e migliorano la procedura di restauro rispetto ai compositi tradizionali a stratificazione incrementale, soprattutto nei settori posteriori. Grazie alla loro chimica, è stato superato il problema dello stress da contrazione e pertanto possono essere usati in un incremento unico. Ma che cosa distingue alcuni compositi bulk da altri?
Utilizzo di un nuovo sistema a pressione negativa apicale per la detersione e la...
di Edith Samano, DDS, Ana Maria Gonzales, MC, Manuel Silva-Hertzog, DDS, MSD, Antonio Aragón Pina, PhD
Universidad Autonoma de San Luis de Potosi, México Dipartimento...